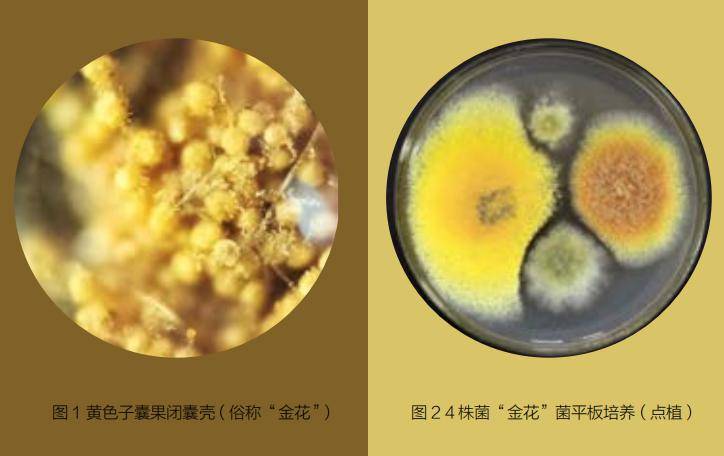
普洱茶中的金花研究_子囊_品质_茶叶

子囊菌门

实验一子囊菌门代表菌和丝孢菌个体形态观察.ppt
图片尺寸800x600
子囊菌门的分类
图片尺寸553x741
子囊菌亚门
图片尺寸890x1013
子囊菌.
图片尺寸1200x797
子囊菌亚门
图片尺寸796x1111
子囊菌门(1)
图片尺寸1080x810
子囊菌门
图片尺寸300x293
实验一子囊菌门代表菌和丝孢菌个体形态观察.ppt
图片尺寸800x600
子囊菌.
图片尺寸1200x799
子囊菌亚门
图片尺寸754x588
子囊菌 半知菌
图片尺寸1080x810
子囊菌门
图片尺寸220x164
p>子囊菌亚门(ascomycotina) 真菌门中最大的一亚门.
图片尺寸750x750
p>子囊菌亚门(ascomycotina) 真菌门中最大的一亚门.
图片尺寸750x750
p>子囊菌亚门(ascomycotina) 真菌门中最大的一亚门.
图片尺寸751x750
p>子囊菌亚门(ascomycotina) 真菌门中最大的一亚门.
图片尺寸750x749
内孢霉目_半子囊菌纲_子囊菌亚门_子囊菌门_真菌界_真核生物域_四域
图片尺寸800x599
p>子囊菌亚门(ascomycotina) 真菌门中最大的一亚门.
图片尺寸750x750
p>子囊菌亚门(ascomycotina) 真菌门中最大的一亚门.
图片尺寸300x180
普洱茶中的金花研究_子囊_品质_茶叶
图片尺寸724x456